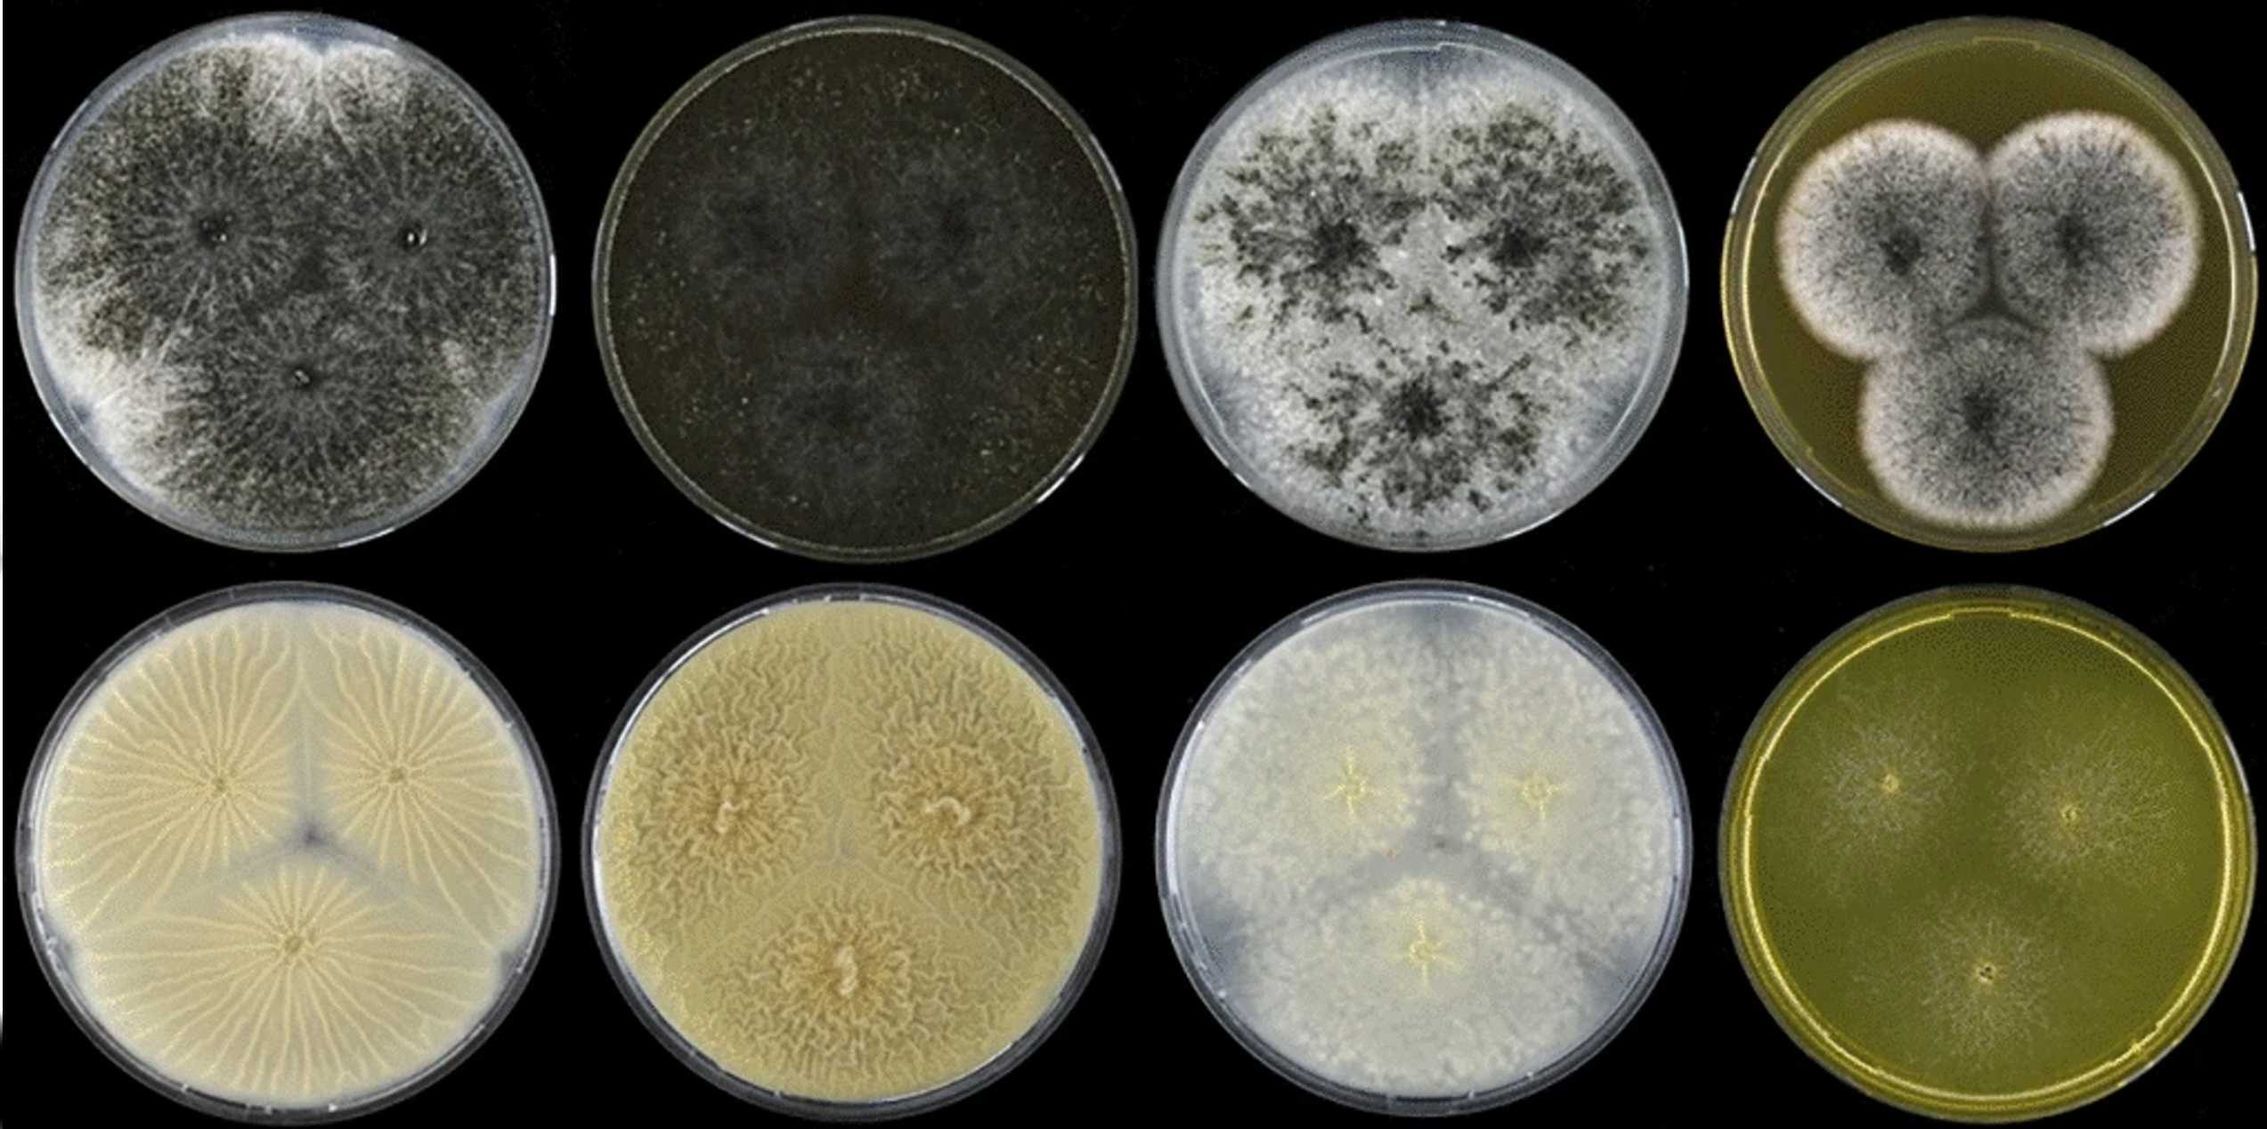
Pocta pro českého vědce. Nově objevenou houbu pojmenovali po Vítu Hubkovi

před rokem od Aktuálně.cz
Pocta pro českého vědce. Nově objevenou houbu pojmenovali po Vítu Hubkovi
Mikrobiologovi a mykologovi Hubkovi je 38 let, v historii bylo takto mladému vědci málokdy uděleno podobné uznání.
Pokračovat na článek








